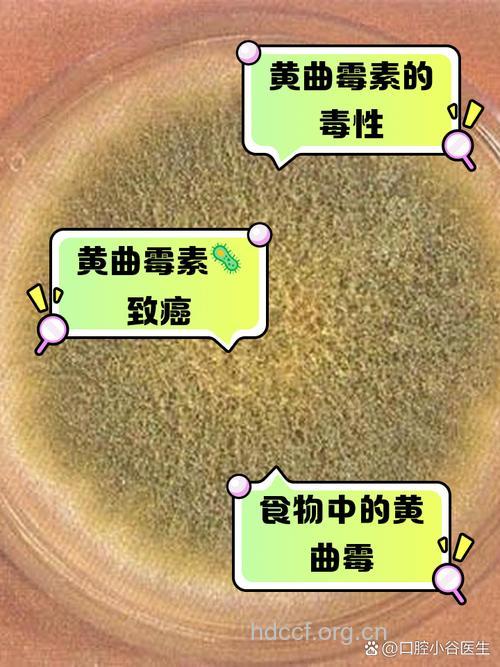
什么东西吃错比砒霜还毒

1、生豆浆
致命毒素:皂素
致使机理:由于生大豆中也含有毒成分,因此,如果豆浆未煮熟时就食用,也可引起食物中毒。特别是将豆浆加热至80℃左右时,皂素受热膨胀,泡沫上浮,形成“假沸”现象,其实此时存在于豆浆中的皂素等有毒害成分并没有完全破坏,如果饮用这种豆浆即会引起中毒,通常在食用0.5~1小时后即可发病,主要出现胃肠炎症状。
解毒方法:为了防止饮用生豆浆中毒,在煮豆浆时,出现“假沸”后还应继续加热至100℃。煮熟的豆浆没有泡沫。
2、新鲜木耳
致命毒素:啉类光感物质
致命机理:鲜木耳含有一种啉类光感物质,它对光线敏感,食用后经太阳照射,引起日光皮炎,个别严重的还会因咽喉水肿发生呼吸困难。
解毒方法:不可食用。
3、发芽马铃薯
致命毒素:茄碱
致命机理:马铃薯是家庭餐桌上经常食用的蔬菜之一,但它含有毒成分茄碱(马铃薯毒素、龙葵苷),马铃薯全株都含有这种毒素,不过,各部位含量不同,成熟马铃薯含量较少,一般不引起中毒,而马铃薯的芽、花、叶及块茎的外层皮中却含有较高的茄碱,马铃薯嫩芽部位的毒素甚至比肉质部分高几十倍至几百倍。未成熟的绿色马铃薯或因贮存不当而出现黑斑的马铃薯块茎中,都含有极高的毒性物质。
解毒方法:为了防止马铃薯中毒,我们可将马铃薯贮藏在干燥阴凉的地方,防止发芽。吃时,如果发现发芽或皮肉呈黑绿色时,最好不要食用。
4、青菜
致命毒素:亚硝酸盐
致命机理:青菜中的荠菜、灰菜等野菜都含有大量亚硝酸盐。如果人体摄入过量亚硝酸盐,可将人体内正常的血红蛋白氧化成高铁血红蛋白,此外,亚硝酸盐还可阻止氧合血红蛋白释放氧,从而引起组织机体缺氧,使人发生中毒。
解毒方法:那么,怎样才能预防亚硝酸盐中毒呢?其实很简单,一定要让家人食用新鲜菜,煮熟的菜不宜久闷存放,腌菜应在腌制一个月以后洗涤后才可食用。
5、四季豆
致命毒素:皂素
致命机理:如果四季豆未煮熟,豆中的皂素会强烈刺激消化道,而且豆中含有凝血素,具有凝血作用。此外四季豆中还含有亚硝酸盐和胰蛋白酶,可刺激人体的肠胃,使人食物中毒,出现胃肠炎症状。
解毒方法:为了防止出现四季豆中毒,一定要将四季豆煮透、煮熟。
6、蚕豆
致命毒素:巢菜碱苷
致命机理:蚕豆种子中含有巢菜碱苷,人食用这种物质后,可引起急性溶血性贫血(蚕豆黄病)。春夏两季吃青蚕豆时,如果烹制不当,常会使人发生中毒现象。而且一般在吃生蚕豆后4~24小时后发病。
解毒方法:为了防止出现蚕豆中毒,最好不要吃新鲜的嫩蚕豆,而且一定要煮熟后再食用。
7、黄花菜
致命毒素:秋水仙碱
致命机理:黄花菜又被称为金针菜,是人们喜爱的菜肴之一。但黄花菜中含有秋水仙碱,如果人体摄入秋水仙碱后,会在人体组织内被氧化,生成二秋水仙碱。而二秋水仙碱是一种剧毒物质,可毒害人体胃肠道、泌尿系统,严重威胁健康。一个成年人如果一次食入鲜黄花菜50~100克即可引起中毒。
解毒方法:要防止出现鲜黄花菜中毒,可将鲜黄花菜在沸水中稍煮片刻,再用清水浸泡,就可将大部分水溶性秋水仙碱去除。也可将鲜黄花菜煮熟、煮透,再烹调食用。
8、蓝紫色的紫菜
致命毒素:环状多肽
致命机理:紫菜水发后若呈蓝紫色,则说明在海中生长时已被有毒物质环状多肽污染。
解毒方法:这些毒素蒸煮也不能解毒,不可食用。
9、十字花科类蔬菜
致命毒素:芥子油
致命机理:十字花科类蔬菜包括油菜、芥菜、萝卜等,这类蔬菜大多含有芥子油苷,这种芥子油苷是一种可阻止人体生长发育和致甲状腺肿的毒素。不同的蔬菜,或同一种蔬菜的不同部位含芥子油苷含量差别也很大,如果处理不好,可能会使人们出现甲状腺肿大、代谢紊乱,出现中毒症状,甚至死亡。
解毒方法:那么,怎样处理这类蔬菜呢?在烹制此类蔬菜时,可用沸水先焯一下再食用。
10、木薯
致命毒素:亚麻仁苦苷
致命机理:尽管木薯的块根富含淀粉,但其全株各部位,包括根、茎、叶都含有毒物质,而且新鲜块根毒性较大。因此,在食用木薯块根时一定要注意。木薯含有的有毒物质为亚麻仁苦苷,如果摄入生的或未煮熟的木薯或喝其汤,都有可能引起中毒。其原因为亚麻仁苦苷或亚麻仁苦苷酶经胃酸水解后产生游离的氢氰酸,从而使人体中毒。一个人如果食用150~300克生木薯即可引起中毒,甚至死亡。
解毒方法:要防止木薯中毒,可在食用木薯前去皮,用清水浸薯肉,使氰苷溶解。一般泡6天左右就可去除70%的氰苷,再加热煮熟,即可食用。